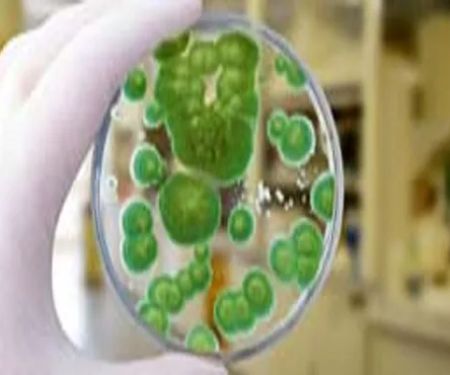
ALL US Mold Removal & Remediation - Frisco TX

Restoration XP Photos










Restoration XP Introduce
When disaster strikes, whether it’s a sudden flood from a burst pipe, the aftermath of a fire, or a hidden mold problem, Texans know the importance of having a reliable and responsive team on their side. In the Dallas-Fort Worth metroplex, Restoration XP has established itself as a leading authority in property restoration and disaster recovery. They are not just a service provider; they are a dedicated partner who understands the stress and challenges that come with home and business damage. This article will provide an in-depth look at Restoration XP, highlighting their comprehensive services, professional approach, and the reasons why they have become a trusted name for locals in need.
The unique climate of North Texas, with its severe storms, high humidity, and fluctuating temperatures, means that property owners are often at risk for damage. A strong hailstorm can puncture a roof, a plumbing leak can go unnoticed for days, and the Texas heat can create ideal conditions for mold growth. Restoration XP is specifically equipped to handle these local challenges. Their team of experts is trained and certified to tackle a wide range of issues, ensuring that your property is not just cleaned up, but fully restored to a safe and healthy condition. Their commitment to customer-centered service is evident in every step of the process, from the initial emergency call to the final reconstruction. They truly believe in making a difficult time as smooth as possible for their clients.
One of the most valuable aspects of their service is the peace of mind they provide. When you’re dealing with a crisis, the last thing you want is a complicated, drawn-out process. Restoration XP understands this deeply. As an engineer-owned company, they bring a unique level of expertise and precision to every job. This background means they don't just fix what’s visible; they get to the root of the problem, ensuring a durable and lasting solution. This proactive approach is a significant differentiator and is a testament to their commitment to quality. The glowing reviews from their customers often mention this professional and caring attitude, highlighting how their team goes above and beyond to ease stress and deliver exceptional results.
Restoration XP is conveniently located to serve the vast DFW area. Their main office is at 5700 Granite Pkwy Suite, 200, Plano, TX 75024. This central location in the heart of Plano allows them to deploy their teams quickly and efficiently to homes and businesses across the metroplex. Disaster doesn't wait for business hours, and neither do they. With 24/7 emergency services, Texans can rest assured that help is just a phone call away, day or night. This accessibility is crucial in a region where a quick response can mean the difference between a minor issue and a major, costly repair. Their team is always on standby, ready to respond to water damage, fire damage, and other emergencies, providing an immediate and effective solution.
The range of services offered by Restoration XP is extensive, covering nearly every type of property damage a Texas resident might encounter. They pride themselves on being a full-service company, handling everything from the initial cleanup to the final reconstruction.
- Water Damage Restoration: Whether from a burst pipe, a leaking appliance, or a severe flood, they provide rapid water extraction, structural drying, and dehumidification to prevent further damage and mold growth.
- Mold Remediation: With a focus on health and safety, their certified specialists identify, contain, and safely remove mold infestations. They also offer preventative measures to ensure the mold does not return.
- Fire and Smoke Damage Restoration: After a fire, they handle debris removal, structural repairs, and comprehensive cleaning to eliminate soot and lingering smoke odors, restoring the property to a safe and livable condition.
- Contents Cleaning and Packout: They offer a state-of-the-art facility for cleaning and storing personal belongings affected by fire, water, or mold damage. Their team carefully packs, transports, and restores your valuable items with the utmost care.
- Reconstruction Services: As an engineer-owned company, they provide expert reconstruction services to rebuild and repair a property after a major disaster, ensuring everything is restored to the highest standards.
- Insurance Claims Assistance: They work closely with all insurance providers, helping clients navigate the complex claims process. They document the damage thoroughly and advocate for their clients to ensure they receive the compensation they are owed.
Restoration XP is distinguished by several key features that make them a standout choice for residents and business owners in the DFW area.
- 24/7 Emergency Service: Disasters can happen at any time. Their team is available around the clock, 365 days a year, to respond to emergencies and mitigate damage as quickly as possible.
- Engineer-Owned Company: Their unique engineering background ensures that every restoration and reconstruction project is handled with a level of precision and expertise that few other companies can match.
- Exceptional Customer Communication: Their team, from the field crew to the corporate office, is praised by customers for their constant communication, organization, and professionalism, which helps to alleviate stress during a difficult time.
- Comprehensive and Meticulous Cleanup: They are known for their attention to detail, not only in the restoration work itself but also in the cleanup afterward, leaving the property in pristine condition.
- Trusted Partner in the Community: Restoration XP is an active member of the local community, including a partnership with the Dallas Mavericks, which demonstrates their commitment to giving back and building trust.
For immediate assistance or to learn more about their services, you can reach Restoration XP at the following contact points.
Address: 5700 Granite Pkwy Suite, 200, Plano, TX 75024, USA
Phone: (800) 858-1701
For residents of North Texas, Restoration XP is more than just a restoration company; they are a vital resource. The unpredictability of the local weather and the potential for a wide array of household disasters make a dependable, local partner essential. Their blend of technical expertise, customer-focused care, and swift emergency response makes them an ideal choice. When you’re facing a crisis, you want a team that is not only skilled at what they do but also empathetic to your situation. The testimonials from real customers highlight this human element—the relief and gratitude for a team that restores not just a property, but a sense of normalcy and security. For locals, choosing Restoration XP means choosing a company that truly understands the value of a safe home and is dedicated to restoring it with care and precision, every single time.
Restoration XP Services
Water Damage Restoration Service
- Carpet cleaning
- Fire damage cleanup & repair
Expert fire damage cleanup and repair to restore safety, structure, and comfort to your property after a fire. We remove soot, smoke odor, and debris, then repair and rebuild affected areas, ensuring your home or business is clean, safe, and ready for use again.
- Flood cleanup
- Flood restoration
- Flooring
- Mold remediation
- Painting
- Plumbing
- Water damage-related cleanup & repair
Fast, professional water damage cleanup and repair services to restore your home or business after leaks, floods, or storms. Our team removes standing water, dries affected areas, and repairs damage to prevent mold, structural issues, and costly future problems.
- Water removal
- 24/7 Emergency Water Damage Restoration Service
- Appliance Leak Restoration Services
- Appliance Leaks
- Asbestos Removal
- Assessment And Documentation
- Basement Waterproofing
- Biohazard and Decontamination Cleanup
- Board Up And Tarping Services
- Board Up Services
- Broken Pipes
- Building Dry Out Services
- Building Repair
- Burst Pipe Repair
- Burst Water Pipe Repair
- Business Restored
- Certifications Restoration
- Commercial Building
- Commercial Covid 19 Disinfecting
- Commercial Mold Remediation Services
- Commercial Property
- Complete Dry
- Complete Smoke Damage Cleanup
- Comprehensive Reconstruction Services
- Construction Restoration
- Contents Cleaning & Restoration
- Contents Storage
- Damage Remediation
- Disaster Recovery Services
- Disaster Restoration
- Disaster Restoration Restoration
- Dispute Resolution
- Dry Out Services
- Efficient Water Removal
- Emergency Board Ups
- Emergency Dry Out
- Emergency Plumbing
- Emergency Response
24/7 emergency restoration response for water, fire, or storm damage. Our trained team arrives fast, assesses the situation, and takes immediate action to minimize loss, protect your property, and start the cleanup and repair process without delay.
- Emergency Service Call
- Emergency Water Extraction And Dry Out
- Fire And Mold Damage
- Fire And Smoke Damage Restoration
- Fire Clean Up
- Fire Damage Assessment
- Fire Rebuild
- Flood Damage Restoration
- Flooded Basement Cleanup
- Flooded Bathroom
- Free Estimate
- Free Inspection
- Hail Damage
- Hail Damage Repair
- Hail Damage Restoration
- Hardwood Floors
- Hvac System
- Insurance Claims
- Leaking Pipe
- Mold Damage Restoration
- Mold Detection
- Mold Removal
Safe, thorough mold removal services to protect your health and restore clean indoor air. Our specialists locate and remove mold at the source, treat affected areas, and help prevent future growth for a healthier, safer home or workplace environment.
- Natural Disaster Cleanup
- Natural Disasters
- Pack Out And Moving
- Property Damage
- Property Management
- Property Restoration
- Regular Maintenance
- Residential Or Commercial
- Restoration & Remediation
- Restoration & Repair
- Restoration Dry
- Restoration Projects
- Restoration Services Available 24/7
- Roof Leaks
- Secure Storage
- Site Cleanup
- Slab Leak
- Smoke Damage
- Soot Cleanup
- Structural Damage
- Structural Repairs
- Structure Dry
- Surface Dry
- Temporary Electrical
- Toilet Overflow
- Toilet Overflow Cleanup
- Toilet Overflow Cleanup and Repair
- Trauma Scene Cleanup
- Ventilation Systems
- Viral Disinfection
- Wall And Ceiling Cleaning
- Water Damage Cleanup
- Water Damage Remediation Service
Complete water damage remediation to address flooding, leaks, or burst pipes. We extract water, dry affected spaces, repair damage, and implement safeguards to prevent future issues, helping you return your home or business to a safe, restored condition.
- Water Heater Leak Repair
- Water Heater Repair
- Water Intrusion
- Water Mitigation
- Water damage repair
- Water leak damage repair
- Water, Fire And Mold Damage
Restoration XP Details
Service options
- Online estimates
- Onsite services
Accessibility
- Wheelchair accessible entrance
- Wheelchair accessible parking lot
Restoration XP Location
Restoration XP
5700 Granite Pkwy Suite, 200, Plano, TX 75024, USA
Restoration XP Reviews
jobproject managermoneyreviewfurnitureintegrityleadershiprenovationhotelcontract
★ 5★ 4★ 3★ 2★ 1I can’t say enough good things about Matt Burns and his team as they did the impossible in my mind. They remediated a major mold issue caused by an incompetent flooring company that put the wrong moisture barrier down which caused black mold to grow (see pics) Matt really restored my faith in people that do care and are not unethical just looking to make a buck at the expense of the costumer. I thought all my cabinets needed to removed but Matt had a plan and it worked out perfectly! No cabinets removed and all mold cleared and house tested for safety. I would 100% recommend using Restoration XP again as well as to anyone asking. Clean, professional and top notch customer service! Give these guys a raise!
Jun 11, 2025 · Kurt BuckHuge thanks to the entire service team at Restoration XP who supported us through every step of our home project—with care, dedication, and attention to detail. From cleanup to unpacking, your professionalism truly made a difference.And a sincere thanks to Priscilla & her fearless crew! Her leadership, organization, and constant communication kept everything on track and helped ease so much of our stress. She truly led by example, and it showed in every detail.We couldn’t have asked for a better group of people. From the delivery crew to the unpacking team—and everyone at the corporate office. We’re truly grateful to each and every one of you!
Jun 20, 2025 · Hanhna GibbonsArthur came out while my house was still burning. Was very patient and understanding. When he was not available to come back out and meet us he sent Ronny to us. Ronny was very helpful and informative. Set us up with starting our claim and the boarding process.
Jul 21, 2025 · Jacqueline IngramDaylontae was professional, courteous, polite and kind He explained the work they would do and performed as expected. He checked on us everyday. No upcharges or surprises. He was a pleasure to work with. Matt was the person I spoke with in the phone. He gave me the price and answers my questions. No pressures update and everything we discussed was included in the price. I was very satisfied with their work. Not happy I had water damage but very happy I worked with this company.
Jul 28, 2025 · Adrienne Broadwater⸻⭐️⭐️⭐️⭐️⭐️From day one, Arthur has been an absolute lifesaver—walking us through every step of the restoration process with professionalism, patience, and clear communication. He truly went above and beyond to make a stressful situation feel manageable. Emily has also been a huge help, always responsive and incredibly supportive throughout the entire process. We couldn’t have asked for a better team. Highly recommend this company for anyone in need of restoration services!
Jun 16, 2025 · Kat Webber
More Water Damage Restoration Near Me
 Restoration Experts5.0 (2 reviews)
Restoration Experts5.0 (2 reviews)8053 Cornelius Dr., Plano, TX 75024, USA
 SS Water Restoration5.0 (107 reviews)
SS Water Restoration5.0 (107 reviews)5700 Tennyson Pkwy Suite 332, Plano, TX 75024, USA
 Elite0.0 (0 reviews)
Elite0.0 (0 reviews)6860 Dallas Pkwy, Plano, TX 75024, USA
 SERVPRO of Central and West Plano4.0 (114 reviews)
SERVPRO of Central and West Plano4.0 (114 reviews)7800 Preston Rd # 132, Plano, TX 75024, USA
ALL US Mold Removal & Remediation - Frisco TX5.0 (1 reviews)
ALL US Mold Removal & Remediation - Frisco TX5.0 (1 reviews)1701 Legacy Dr, Frisco, TX 75034, USA
 Dry Force Water Removal Specialists4.0 (381 reviews)
Dry Force Water Removal Specialists4.0 (381 reviews)7460 Warren Pkwy #161, Frisco, TX 75034, USA
 Right Away Restoration5.0 (1 reviews)
Right Away Restoration5.0 (1 reviews)8908 Ohio Dr, Plano, TX 75024, USA
 Real Restoration Solutions4.0 (48 reviews)
Real Restoration Solutions4.0 (48 reviews)5 Cowboys Way, Frisco, TX 75034, USA
 Pineapple Restorations0.0 (0 reviews)
Pineapple Restorations0.0 (0 reviews)1 Cowboys Way Suite 270W, Frisco, TX 75034, USA
 Spotless Carpet Cleaning and Restoration4.0 (109 reviews)
Spotless Carpet Cleaning and Restoration4.0 (109 reviews)4900 Preston Rd Unit A, Frisco, TX 75034, USA
 Home Recovery Solutions4.0 (42 reviews)
Home Recovery Solutions4.0 (42 reviews)2400 Dallas Pkwy Suite 450, Plano, TX 75093, USA
 DRYmedic of Plano5.0 (15 reviews)
DRYmedic of Plano5.0 (15 reviews)6950 Eubanks St B-8, Frisco, TX 75034, USA
Categories
Top Visited Sites
 OMG Sanitized, Inc.5.0 (37 reviews)
OMG Sanitized, Inc.5.0 (37 reviews) Operation Restoration5.0 (33 reviews)
Operation Restoration5.0 (33 reviews) Property Doctors, Inc.4.0 (14 reviews)
Property Doctors, Inc.4.0 (14 reviews) Rainbow International of Los Feliz5.0 (4 reviews)
Rainbow International of Los Feliz5.0 (4 reviews) Sumner5.0 (22 reviews)
Sumner5.0 (22 reviews) Augmented Mold Removal & Remediation Union City CA5.0 (1 reviews)
Augmented Mold Removal & Remediation Union City CA5.0 (1 reviews)Top Water Damage Restoration Searches
Trending Damage Repair Guides Posts
 How to Repair Water-Damaged Wall Panels: A Step-by-Step Guide
How to Repair Water-Damaged Wall Panels: A Step-by-Step Guide Signs You Need Immediate Water Damage Repair: Quick Action Tips
Signs You Need Immediate Water Damage Repair: Quick Action Tips What You Need to Know About Water Damage and Your Home Insurance: A Complete Guide
What You Need to Know About Water Damage and Your Home Insurance: A Complete Guide Water Damage Restoration for Schools and Educational Buildings
Water Damage Restoration for Schools and Educational Buildings Water Damage Restoration for Multi-Family Homes: A Comprehensive Guide
Water Damage Restoration for Multi-Family Homes: A Comprehensive Guide How to Restore Water-Damaged Wooden Furniture
How to Restore Water-Damaged Wooden Furniture
